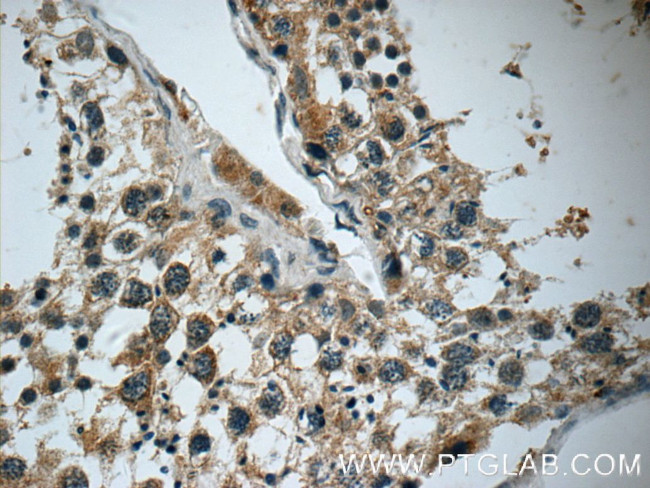
DARS2 Antibody in Immunohistochemistry (Paraffin) (IHC (P))

Search
Proteintech
DARS2 Polyclonal Antibody
{{$productOrderCtrl.translations['antibody.pdp.commerceCard.promotion.promotions']}}
{{$productOrderCtrl.translations['antibody.pdp.commerceCard.promotion.viewpromo']}}
{{$productOrderCtrl.translations['antibody.pdp.commerceCard.promotion.promocode']}}: {{promo.promoCode}} {{promo.promoTitle}} {{promo.promoDescription}}. {{$productOrderCtrl.translations['antibody.pdp.commerceCard.promotion.learnmore']}}
产品信息
13807-1-AP
种属反应
已发表种属
宿主/亚型
分类
类型
抗原
偶联物
形式
浓度
规格
纯化类型
保存液
内含物
保存条件
运输条件
产品详细信息
Immunogen sequence: LIEGLLQYS WPNDKDPVVV PFPTMTFAEV LATYGTDKPD TRFGMKIIDI SDVFRNTEIG FLQDALSKPH GTVKAICIPE GAKYLKRKDI ESIRNFAADH FNQEILPVFL NANRNWNSPV ANFIMESQRL ELIRLMETQE EDVVLLTAGE HNKACSLLGK LRLECADLLE TRGVVLRDPT LFSFLWVVDF PLFLPKEENP RELESAHHPF TAPHPSDIHL LYTEPKKARS QHYDLVLNGN EIGGGSIRIH NAELQRYILA TLLKEDVKML SHLLQALDYG APPHGGIALG LDRLICLVTG SPSIRDVIAF PKSFRGHDLM SNTPDSVPPE ELKPYHIRVS KPTDSKAERA H (296-645 aa encoded by BC045173)
靶标信息
The protein encoded by this gene belongs to the class-II aminoacyl-tRNA synthetase family. It is a mitochondrial enzyme that specifically aminoacylates aspartyl-tRNA. Mutations in this gene are associated with leukoencephalopathy with brainstem and spinal cord involvement and lactate elevation (LBSL).
仅用于科研。不用于诊断过程。未经明确授权不得转售。
生物信息学
蛋白别名: aspartate tRNA ligase 2, mitochondrial; Aspartate--tRNA ligase, mitochondrial; Aspartyl-tRNA synthetase; aspartyl-tRNA synthetase, mitochondrial; AspRS; unnamed protein product
基因别名: 5830468K18Rik; ASPRS; DARS2; LBSL; MT-ASPRS; mtAspRS; RGD1308286
UniProt ID: (Human) Q6PI48, (Rat) Q3KRD0, (Mouse) Q8BIP0
Entrez Gene ID: (Human) 55157, (Rat) 304919, (Mouse) 226539